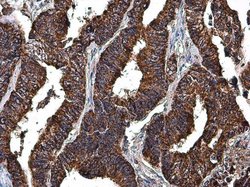
Invitrogen LRP130 Polyclonal Antibody 100 &mu;L | Buy Online | Invitrogen&trade; | Fisher Scientific

missing translation for 'onlineSavingsMsg'
Learn More
Learn More
Invitrogen™ LRP130 Polyclonal Antibody


Descripción
Recommended positive controls: H1299, HeLa, mouse brain. Predicted reactivity: Mouse (84%), Rat (85%). Store product as a concentrated solution. Centrifuge briefly prior to opening the vial.
This gene encodes a deadenylase that functions as the catalytic subunit of the polyadenylate binding protein dependent poly(A) nuclease complex. The encoded protein is a magnesium dependent 3' to 5' exoribonuclease that is involved in the degradation of cytoplasmic mRNAs. Alternate splicing results in multiple transcript variants.

Especificaciones
Especificaciones
| Antígeno | LRP130 |
| Aplicaciones | Immunohistochemistry (Paraffin), Western Blot, Immunocytochemistry |
| Clasificación | Polyclonal |
| Concentración | 0.36 mg/mL |
| Conjugado | Unconjugated |
| Formulación | PBS with 1% BSA, 20% glycerol and 0.025% ProClin 300; pH 7 |
| génica | LRPPRC |
| N.º de referencia del gen | P42704, Q6PB66 |
| Alias de gen | 130 kDa leucine-rich protein; 3110001K13Rik; C76645; CLONE-23970; GP130; leucine rich pentatricopeptide repeat containing; leucine rich protein 157; leucine rich protein LRP130; leucine-rich pentatricopeptide repeat containing; leucine-rich PPR motif-containing protein, mitochondrial; leucine-rich PPR-motif containing; leucine-rich protein 157; LRP 130; LRP130; Lrp157; Lrpprc; LSFC; mitochondrial leucine-rich PPR motif-containing protein; rLRP157 |
| Símbolos de los genes | LRPPRC |
| Mostrar más |
Título del producto
Al hacer clic en Enviar, acepta que Fisher Scientific se ponga en contacto con usted en relación con los comentarios que ha proporcionado en este formulario. No compartiremos su información para ningún otro fin. Toda la información de contacto proporcionada se mantendrá de acuerdo con nuestra Política de Privacidad. Política de privacidad.
¿Detecta una oportunidad de mejora?